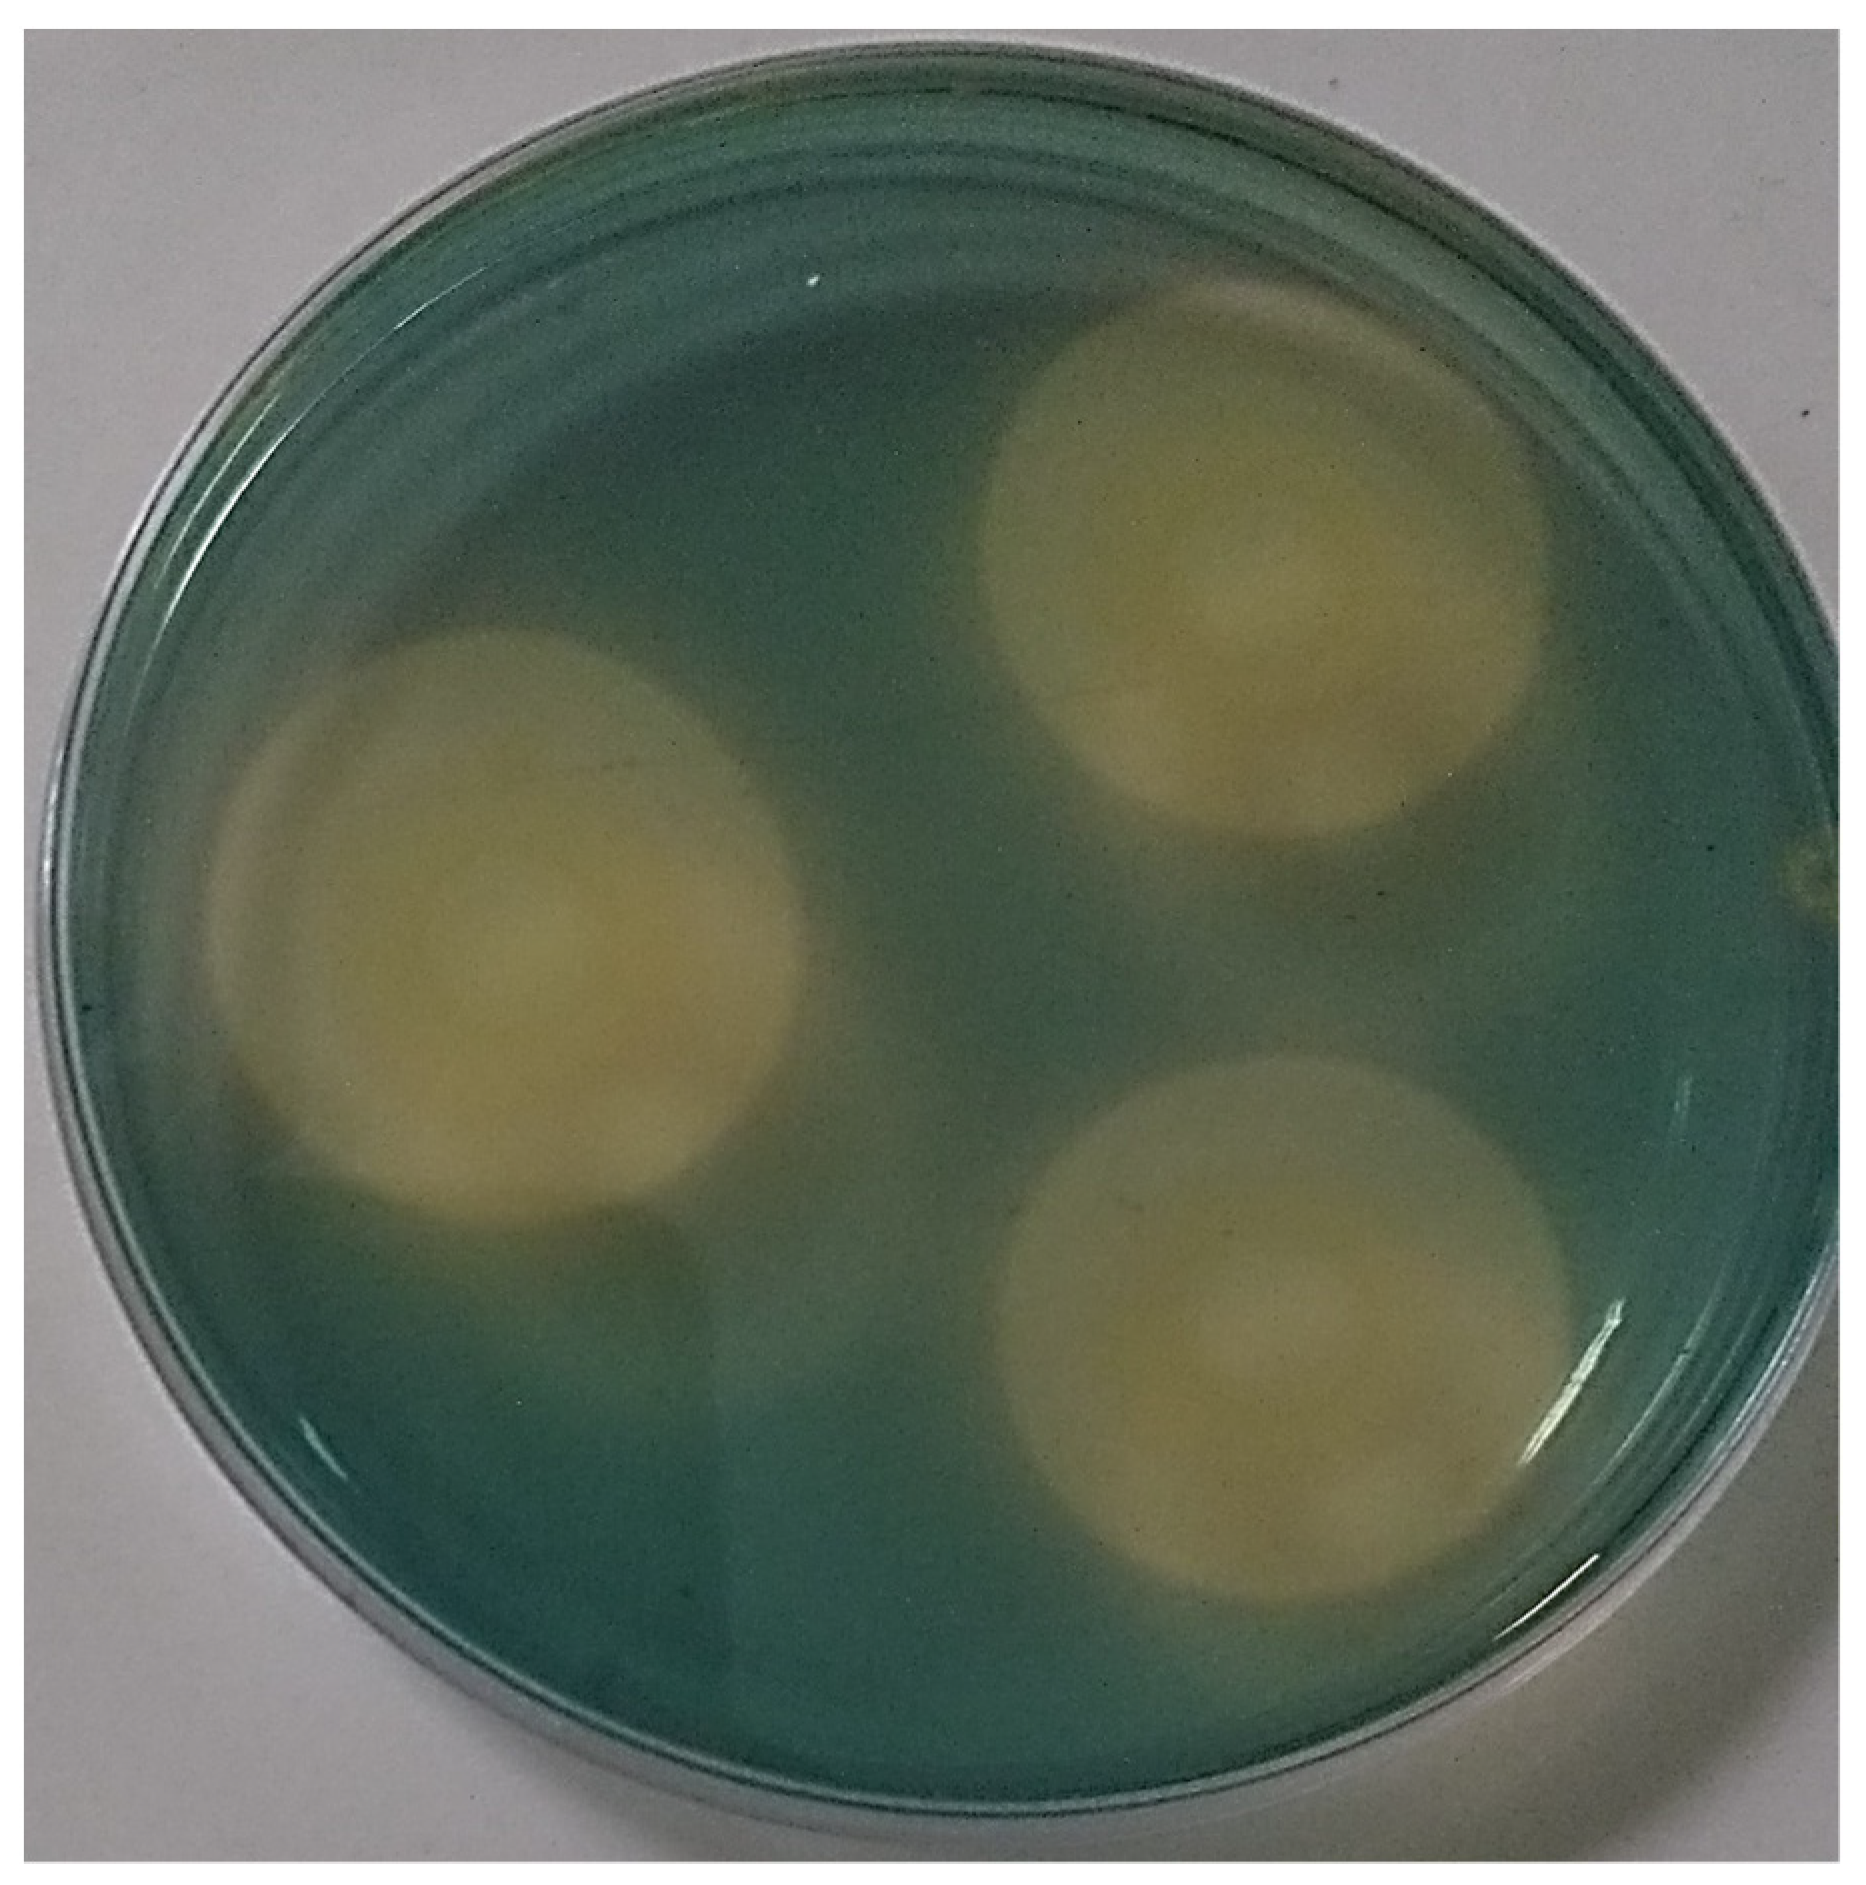
Microorganisms 11 01596 g004 Microorganisms 11 01596 g004

Role of Rahnella aquatilis AZO16M2 in Phosphate Solubilization and Ex Vitro Acclimatization of Musa acuminata var. Valery
Abstract
1. Introduction
2. Materials and Methods
2.1. Semi-Quantitative Estimation of Phosphate Solubilization Capacity: Effects of Temperature and Initial pH of the Medium
2.2. Quantitative Estimation of Phosphate Solubilizing Capacity
2.3. Determination of Siderophores
2.4. Quantification of Acid and Alkaline Phosphatases
2.5. Quantification of Indole Acetic Acid (IAA)
2.6. Presence of the PQQ Gene Involved in Phosphate Solubilization
2.7. Provenance of Clones of Musa Acuminata var. Valery in Nursery
2.8. Transplanting, Irrigation and Fertilization
2.9. Statistical Analysis and Experimental Design
2.10. Parameters Evaluated
3. Results
3.1. Effect of Temperature and Initial pH in Solid Medium
3.2. Quantification of Available Phosphorus and pH Evolution
3.3. Synthesis of Siderophores, Phosphatases, AIA and Organic Acids
3.4. Presence of the PQQ Gene Involved in Phosphate Solubilization
3.5. Response of M. acuminata var. Valery in Association with Phosphate-Solubilizing PGPR Bacteria in a Sand:Vermiculite Substrate
3.6. Response of M. acuminata var. Valery in Association with Phosphate-Solubilizing PGPR Bacteria in PREMIX® N°8 Substrate
4. Discussion
5. Conclusions
Author Contributions
Funding
Data Availability Statement
Acknowledgments
Conflicts of Interest
References
- Lareen, A.; Burton, F.; Schäfer, P. Plant root-microbe communication in shaping root microbiomes. Plant Mol. Biol. 2016, 90, 575–587. [Google Scholar] [CrossRef] [PubMed]
- Kaur, G.; Sudhakara, M. Influence of P-solubilizing bacteria on crop yield and soil fertility at multilocational sites. Eur. J. Soil Biol. 2014, 61, 35–40. [Google Scholar] [CrossRef]
- Ahmad, M.; Ahmad, M.; El-Naggar, A.H.; Usman, A.R.; Abduljabbar, A.; Vithanage, M.; Elfaki, J.; Abdulelah, A.F.; Al-Wabel, M.I. Aging effects of organic and inorganic fertilizers on phosphorus fractionation in a calcareous sandy loam soil. Pedosphere 2018, 28, 873–883. [Google Scholar] [CrossRef]
- Babá, C.; Nahas, E. Solubilização do fosfato de ferro em meio de cultura. Pesqueira Agropecu. Bras. 2008, 43, 529–535. [Google Scholar] [CrossRef]
- Malhotra, H.; Sharma, S.; Pandey, R. Phosphorus nutrition: Plant growth in response to deficiency and excess. In Plant Nutrients and Abiotic Stress Tolerance; Hasanuzzaman, M., Fujita, M., Oku, H., Nahar, K., Hawrylak-Nowak, B., Eds.; Springer: Singapore, 2018; pp. 171–190. [Google Scholar] [CrossRef]
- Babá, C.; Nahas, E. Enhanced Solubilization of Iron and Calcium phosphates by Aspergillus niger by the Addition of Alcohols. Braz. Arch. Biol. Technol. 2013, 56, 181–189. [Google Scholar] [CrossRef]
- Rooney, D.; Clipson, N. Phosphate addition and plant species alters microbial community structure in acidic upland grassland soil. Microb. Ecol. 2009, 57, 4–13. [Google Scholar] [CrossRef]
- Beltrán, M. La solubilización de fosfatos como estrategia microbiana para promover el crecimiento vegetal. Corpoica Cienc. Tecnol. Agropecu. 2014, 15, 101–113. [Google Scholar] [CrossRef]
- Xiaolong, L.; Lijin, L.; Jinshui, Y.; Baozhen, L.; Hongli, Y. Mechanisms for Solubilization of Various Insoluble Phosphates and Activation of Immobilized Phosphates in Different Soils by an Efficient and Salinity-Tolerant Aspergillus niger Strain An2. Appl. Biochem. Biotechnol. 2015, 175, 2755–2768. [Google Scholar] [CrossRef]
- Chang, C.H.; Yang, S.S. Thermo-tolerant phosphate-solubilizing microbes for multi-functional biofertilizer preparation. Bioresour. Technol. 2009, 100, 1648–1658. [Google Scholar] [CrossRef]
- Deng, Y.; Teng, W.; Tong, Y.-P.; Chen, X.-P.; Zou, C.-Q. Phosphorus efficiency mechanisms of two wheat cultivars as affected by a range of phosphorus levels in the field. Front. Plant Sci. 2018, 9, 1614. [Google Scholar] [CrossRef]
- Bindraban, P.S.; Dimkpa, C.O.; Pandey, R. Exploring phosphorus fertilizers and fertilization strategies for improved human and environmental health. Biol. Fertil. Soils 2020, 56, 299–317. [Google Scholar] [CrossRef]
- Banerjee, S.; Palit, R.; Sengupta, C.; Standing, D. Stress induced phosphate solubilization by Arthrobacter sp. and Bacillus sp. Isolated from tomato rhizosphere. Aust. J. Crop Sci. 2010, 4, 378–383. [Google Scholar]
- Krishnaraj, P.; Goldstein, A. Cloning of a Serratia marcescens DNA fragment that induces quinoprotein glucose dehydrogenase-mediated gluconic acid production in Escherichia coli in the presence of stationary phase Serratia marcescens. FEMS Microbiol. Lett. 2001, 205, 215–220. [Google Scholar] [CrossRef] [PubMed]
- Beever, R.E.; Burns, D.J.W. Phosphate uptake, storage and utilization by fungi. Adv. Bot. Res. 1980, 8, 127–219. [Google Scholar] [CrossRef]
- Bargaz, A.; Elhaissoufi, W.; Khourchi, S.; Benmrid, B.; Borden, K.A.; Rchiad, Z. Benefits of phosphate solubilizing bacteria on belowground crop performance for improved crop acquisition of phosphorus. Microbiol. Res. 2021, 252, 126842. [Google Scholar] [CrossRef]
- Delvasto, P.; Valverde, A.; Ballester, A.; Igual, J.M.; Muñoz, J.A.; González, F.; Blázquez, M.L.; García, C. Characterization of brushite as a re-crystallization product formed during bacterial solubilization of hydroxyapatite in batch cultures. Soil Biol. Biochem. 2006, 38, 2645–2654. [Google Scholar] [CrossRef]
- Hong-Joo, S.; Geun-Tae, P.; Mi-Sun, C.; Moon-Soo, H. Solubilization of insoluble inorganic phosphates by a novel salt- and pH-tolerant Pantoea agglomerans R-42 isolated from soybean rhizosphere. Bioresour. Technol. 2006, 97, 204–210. [Google Scholar] [CrossRef]
- Sharma, S.B.; Sayyed, R.Z.; Trivedi, M.H.; Gobi, T.A. Phosphate solubilizing microbes: Sustainable approach for managing phosphorus deficiency in agricultural soils. SpringerPlus 2013, 2, 587. [Google Scholar] [CrossRef]
- Rodríguez, H.; Fraga, R.; Gonzales, T.; Bashan, Y. Genetics of phosphate solubilization and its applications bacteria for im-proving plant growth-promoting. Plant Soil 2006, 287, 15–21. [Google Scholar] [CrossRef]
- Suleman, M.; Id, S.Y.; Rasul, M.; Yahya, M.; Atta, M.; Mirza, M.S. Phosphate solubilizing bacteria with glucose dehydrogenase gene for phosphorus uptake and beneficial effects on wheat. PLoS ONE 2018, 9, e0204408. [Google Scholar] [CrossRef]
- Emami, S.; Alikhani, H.A.; Pourbabaei, A.A.; Etesami, H.; Sarmadian, F.; Motessharezadeh, B. Effect of rhizospheric and endophytic bacteria with multiple plant growth promoting traits on wheat growth. Environ. Sci. Pollut. Res. 2019, 26, 19804–19813. [Google Scholar] [CrossRef] [PubMed]
- Behera, B.; Singdevsachan, S.; Mishra, R.; Dutta, S.; Thatoi, H. Diversity, mechanism and biotechnology of phosphate solubilizing microorganism in mangrove—A review. Biocatal. Agric. Biotechnol. 2014, 3, 97–110. [Google Scholar] [CrossRef]
- Gyaneshwar, P.; Naresh, G.; Parekh, L.J.; Poole, P.S. Role of soil microorganisms in improving P nutrition of plants. Plant Soil 2022, 245, 83–93. [Google Scholar] [CrossRef]
- Hernández-Leal, T.I.; Carrión, G.; Heredia, G. In vitro phosphate solubilization by a strain of Paecilomyces lilacinus (Thom) Samson. Agrociencia 2011, 45, 881–892. [Google Scholar]
- Ghosh, R.; Soma, B.; Mukherjee, R.; Mandal, N. Role of phosphate solubilizing Burkholderia colonization spp. For successful and growth promotion (Lycopodiaceae) of Lycopodium cernuum L. in lateritic belt of Birbhum district of West Bengal, Indian. Microbiol. Res. 2016, 183, 80–91. [Google Scholar] [CrossRef]
- Oliveira, C.A.; Alves, V.M.C.; Marriel, I.E.; Gomes, E.S.; Scotti, M.R.; Carneiro, N.P.; Guimaraes, C.T.; Schaffert, R.E.; Sá, N.M.H. Phosphate solubilizing microorganisms isolated from rhizosphere of maize cultivated in an oxisol of the Brazilian Cerrado Biome. Soil Biol. Biochem. 2009, 41, 1782–1787. [Google Scholar] [CrossRef]
- Liu, C.; Mou, L.; Yi, J.; Wang, J.; Liu, A.; Yu, J. The Eno gene of Burkholderia cenocepacia strain 71-2 is involved in phosphate solubilization. Curr. Microbiol. 2019, 76, 495–502. [Google Scholar] [CrossRef]
- Billah, M.; Khan, M.; Bano, A.; Hassan, T.U.; Munir, A.; Gurmani, A.R. Phosphorus and phosphate solubilizing bacteria: Keys for sustainable agriculture. Geomicrobiol. J. 2019, 36, 904–916. [Google Scholar] [CrossRef]
- Othman, R.; Panhwar, Q.A. Phosphate-solubilizing bacteria improves nutrient uptake in aerobic rice. In Phosphate Solubilizing Microorganisms; Springer: Cham, Switzerland, 2014; pp. 207–224. [Google Scholar] [CrossRef]
- Hoe, T.K.; Sarmidi, M.R.; Alwee, S.S.R.S.; Zakaria, Z.A. Oil palm and banana root colonization potential of locally isolated nitrogen-fixing and phosphate-solubilizing bacteria. In E3S Web of Conferences; EDP Sciences: Les Ulis, France, 2020; Volume 202, p. 01006. [Google Scholar] [CrossRef]
- Bolfarini, A.C.B.; Putti, F.F.; Souza, J.M.A.; Silva, M.d.S.; Ferreira, R.B.; Leonel, M.; Leonel, S. Yield and nutritional evaluation of the banana hybrid “FHIA-18” as influenced by phosphate fertilization. J. Plant Nutr. 2020, 43, 1331–1342. [Google Scholar] [CrossRef]
- Nyombi, K. Diagnosis and management of nutrient constraints in bananas (Musa spp.). In Fruit Crops; Elsevier: Amsterdam, The Netherlands, 2020; pp. 651–659. [Google Scholar] [CrossRef]
- Lacorte, G.H.; Flamiano, R.S.; Alinsug, M.V.; Tagaloguin, P.M. Screening for Potential Plant Growth-Promoting Rhizobacteria (PGPR) Associated with Five Musa spp. Cultivars in SOCCSKSARGEN, Philippines. J. Eng. Environ. Agric. Res. 2018, 1, 5. [Google Scholar] [CrossRef]
- Sharma, R.; Dahiya, A.; Sindhu, S.S. Harnessing Proficient Rhizobacteria to Minimize the Use of Agrochemicals. Int. J. Curr. Microbiol. Appl. Sci. 2018, 7, 3186–3197. [Google Scholar] [CrossRef]
- Mendapara, P.; Khunt, M.D.; Chaudhari, J. Isolation and Characterization of Multi-trait PGPR from Banana (Musa paradisiaca) Rhizosphere. Int. J. Pure Appl. Biosci. 2020, 8, 37–45. [Google Scholar] [CrossRef]
- Ogata-Gutiérrez, K.; Alvarado, D.; Chumpitaz-Segovia, C.; Zúñiga-Dávila, D. Characterization of plant growth promoting rhizobacteria isolated from the rhizosphere of Peruvian highlands native crops. Int. J. Plant Soil Sci. 2016, 11, 1–8. [Google Scholar] [CrossRef] [PubMed]
- Pande, A.; Pandey, P.; Mehra, S.; Singh, M.; Kaushik, S. Phenotypic and genotypic characterization of phosphate solubilizing bacteria and their efficiency on the growth of maize. J. Genet. Eng. Biotechnol. 2017, 15, 379–391. [Google Scholar] [CrossRef] [PubMed]
- De Oliveira-Longatti, S.M.; Marra, L.M.; Lima Soares, B.; Bomfeti, C.A.; Da Silva, K.; Avelar Ferreira, P.A.; De Souza Moreira, F.M. Bacteria isolated from soils of the western Amazon and from rehabilitated bauxite-mining areas have potential as plant growth promoters. World J. Microbiol. Biotechnol. 2014, 30, 1239–1250. [Google Scholar] [CrossRef]
- Spagnoletti, F.N.; Tobar, N.E.; Di Pardo, A.F.; Chiocchio, V.M.; Lavado, R.S. Dark septate endophytes present different potential to solubilize calcium, iron and aluminum phosphates. Appl. Soil Ecol. 2017, 111, 25–32. [Google Scholar] [CrossRef]
- Murphy, J.; Riley, J.P. A modified single solution method for the determination of phosphate in natural Waters. Anal. Chim. Acta 1992, 27, 31–36. [Google Scholar] [CrossRef]
- Schwyn, B.; Neilands, J.B. Universal chemical assay for the detection and determination of siderophores. Anal. Biochem. 1987, 160, 47–56. [Google Scholar] [CrossRef]
- Louden, B.C.; Haarmann, D.; Lynne, A.M. Use of blue agar CAS assay for siderophore detection. J. Microbiol. Biol. Educ. 2011, 12, 51–53. [Google Scholar] [CrossRef]
- Alka, S.; Kalyani, D.; Shukla, P.K.; Atul, S.; Rubina, L.; Ramteke, P.W. Comparative analysis of production of hydrogen cyanide with production of siderophore and phosphate solubilization activity in plant growth promoting bacteria. Vegetos 2018, 31, 130–135. [Google Scholar] [CrossRef]
- Verma, V.; Joshi, K.; Mazumdar, B. Study of Siderophore Formation in Nodule-Forming Bacterial Species. Res. J. Chem. Sci. 2012, 2, 26–29. [Google Scholar]
- Anzuay, M.S.; Ruiz, M.G.; Ludueña, L.M.; Angelini, J.G.; Barros, G.; Pastor, N.; Taurian, T. Growth promotion of peanut (Arachis mays hypogaea L.) and maize (Zea mays L.) plants by single and mixed solubilizing cultures of efficient phosphate bacteria that are tolerant to abiotic stress and pesticides. Microbiol. Res. 2017, 199, 98–109. [Google Scholar] [CrossRef]
- Pandya, N.D.; Desai, P.V.; Jadhav, H.P.; Sayyed, R.Z. Plant growth-promoting potential of Aspergillus sp. NPF7, isolated from wheat rhizosphere in South Gujarat, India. Environ. Sustain. 2018, 1, 245–252. [Google Scholar] [CrossRef]
- Nithyapriya, S.; Lalitha, S.; Sayyed, R.Z.; Reddy, M.S.; Dailin, D.J.; El Enshasy, H.A.; Suriani, N.L.; Herlambang, S. Production, purification, and characterization of bacillibactin siderophore of Bacillus subtilis and its application for improvement in plant growth and oil content in sesame. Sustainability 2021, 13, 5394. [Google Scholar] [CrossRef]
- Rawat, P.; Das, S.; Shankhdhar, D.; Shankhdhar, S.C. Phosphate-Solubilizing Microorganisms: Mechanism and Their Role in Phosphate Solubilization and Uptake. J. Soil Sci. Plant Nutr. 2020, 21, 49–68. [Google Scholar] [CrossRef]
- Hoagland, D.C.; Arnon, D.L. The Water Culture Methods for Growing Plants without Soil. University of California. 1950. Agricultural Experimental Station Circular N° 347. Available online: https://sayurankitadotcom.files.wordpress.com/2016/04/the-water-culture-method-for-growing-plants-without-soil.pdf (accessed on 17 April 2020).
- Rodríguez, M.; Alcántar, G.; Aguilar, A.; Etchevers, J.; Santizó, J. Estimación de la concentración de nitrógeno y clorofila en tomate mediante un medidor portátil de clorofila. Terra 1998, 16, 135–141. [Google Scholar]
- Khan, N.; Bano, A.; Rahman, M.A.; Guo, J.; Kang, Z.; Babar, M. Comparative physiological and metabolic analysis reveals a complex mechanism involved in drought tolerance in chickpea (Cicer arietinum L.) induced by PGPR and PGRs. Sci. Rep. 2019, 9, 2097. [Google Scholar] [CrossRef]
- Hurtado, E.; González-Vallejos, F.; Roper, C.; Bastías, E.; Mazuela, P. Propuesta para la determinación del contenido de clorofila en hojas de tomate. Idesia 2017, 35, 129–130. [Google Scholar] [CrossRef]
- Liu, Z.; Li, Y.C.; Zhang, S.; Fu, Y.; Fan, X.; Patel, J.S.; Zhang, M. Characterization of phosphate-solubilizing bacteria isolated from calcareous soils. Appl. Soil Ecol. 2015, 96, 217–224. [Google Scholar] [CrossRef]
- Teng, Z.; Chen, Z.; Zhang, Q.; Yao, Y.; Song, M.; Li, M. Isolation and characterization of phosphate solubilizing bacteria from rhizosphere soils of the Yeyahu Wetland in Beijing, China. Environ. Sci. Pollut. Res. 2018, 26, 33976–33987. [Google Scholar] [CrossRef]
- Chawngthu, L.; Hnamte, R.; Lalfakzuala, R. Isolation and characterization of rhizospheric phosphate solubilizing bacteria from wetland paddy field of Mizoram, India. Geomicrobiol. J. 2020, 37, 366–375. [Google Scholar] [CrossRef]
- Matos, A.D.; Gomes, I.C.; Nietsche, S.; Xavier, A.A.; Gomes, W.S.; Dos Santos, J.A.; Pereira, M.C. Phosphate solubilization by endophytic bacteria isolated from banana trees. An. Da Acad. Bras. De Cienc. 2017, 89, 2945–2954. [Google Scholar] [CrossRef] [PubMed]
- Wang, Y.Y.; Li, P.S.; Zhang, B.X.; Wang, Y.P.; Meng, J.; Gao, Y.F.; He, X.M.; Hu, X.M. Identification of phosphate-solubilizing microorganisms and determination of their phosphate-solubilizing activity and growth-promoting capability. BioResources 2020, 15, 2560–2578. [Google Scholar] [CrossRef]
- Hii, Y.S.; San, C.Y.; Lau, S.W.; Danquah, M.K. Isolation and characterisation of phosphate solubilizing microorganisms from peat. Biocatal. Agric. Biotechnol. 2020, 26, 101643. [Google Scholar] [CrossRef]
- Ludueña, L.M.; Anzuay, M.S.; Angelini, J.G.; Barros, G.; Luna, M.F.; Monge, M.P.; Fabra, A.; Taurian, T. Role of bacterial pyrroloquinoline quinone inphosphate solubilizing ability and in plant growth promotion on strain Serratia sp. S119. Symbiosis 2017, 72, 31–43. [Google Scholar] [CrossRef]
- Ingle, K.P.; Padole, D.A. Phosphate solubilizing microbes: An overview. Int. J. Curr. Microbiol. Appl. Sci. 2017, 6, 844–852. [Google Scholar] [CrossRef]
- Maliha, R.; Samina, K.; Najma, A.; Sadia, A.; Farooq, L. Organic acids production and phosphate solubilization by phosphate solubilizing microorganisms under in vitro conditions. Pak. J. Biol. Sci. 2004, 7, 187–196. [Google Scholar] [CrossRef]
- Park, K.H.; Lee, O.M.; Jung, H.I.; Jeong, J.H.; Jeon, Y.D.; Hwang, D.Y.; Lee, C.Y.; Son, H.J. Rapid solubilization of insoluble phosphate by a novel environmental stress—Tolerant Burkholderia vietnamiensis M6 isolated from ginseng rhizospheric soil. Appl. Microbiol. Biotechnol. 2010, 86, 947–955. [Google Scholar] [CrossRef]
- Zaidi, A.; Khan, M.S.; Ahemad, M.; Oves, M.; Wani, P.A. Recent Advances in Plant Growth Promotion by Phosphate Solubilizing Microbes. In Microbial Strategies for Crop Improvement; Khan, M.S., Zaidi, A., Musarrat, J., Eds.; Springer: Berlin/Heidelberg, Germany, 2009; pp. 23–50. [Google Scholar] [CrossRef]
- Li, L.; Chen, R.; Zuo, Z.; Lv, Z.; Yang, Z.; Mao, W.; Liu, Y.; Zhou, Y.; Huang, J.; Song, Z. Evaluation and improvement of phosphate solubilization by an isolated bacterium Pantoea agglomerans ZB. World J. Microbiol. Biotechnol. 2020, 36, 27. [Google Scholar] [CrossRef]
- Sharon, J.A.; Hathwaik, L.T.; Glenn, G.M.; Imam, S.H.; Lee, C.C. Isolation of efficient phosphate solubilizing bacteria capable of enhancing tomato plant growth. J. Soil Sci. Plant Nutr. 2016, 16, 525–536. [Google Scholar] [CrossRef]
- An, R.; Moe, L. Regulation of Pyrroloquinoline Quinone-Dependent Glucose Dehydrogenase Activity in the Model Rhizosphere-Dwelling Bacterium Pseudomonas putida KT2440. Appl. Environ. Microbiol. 2016, 82, 4955–4964. [Google Scholar] [CrossRef] [PubMed]
- Rodríguez, H.; Rossolini, G.M.; Gonzalez, T.; Jiping, L.; Glick, B.R. Isolation of a gene from Burkholderia cepacia IS-16 encoding a protein that facilitates phosphatase activity. Curr. Microbiol. 2000, 140, 362–366. [Google Scholar] [CrossRef]
- Asghar, H.N.; Zahir, Z.A.; Arshad, M. Screening rhizobacteria for improving the growth, yield, and oil content of canola (Brassica napus L.). Aust. J. Agric. Res. 2004, 55, 187–194. [Google Scholar] [CrossRef]
- Khalid, A.; Arshad, M.; Zahir, Z.A. Screening plant growth-promoting rhizobacteria for improving groth and yield of wheat. J. Appl. Microbiol. 2004, 96, 473–480. [Google Scholar] [CrossRef] [PubMed]
- Ahmed, N.; Shahab, S. Phosphate solubilization: Their mechanism genetics and application. Internet J. Microbiol. 2009, 9, 1–19. [Google Scholar] [CrossRef]
- Behera, B.C.; Yadav, H.; Singh, S.K.; Mishra, R.R.; Sethi, B.K.; Dutta, S.K.; Thatoi, H.N. Phosphate solubilization and acid phosphatase activity of Serratia sp. isolated from mangrove soil of Mahanadi River delta, Odisha, India. J. Genet. Eng. Biotechnol. 2017, 15, 169–178. [Google Scholar] [CrossRef]
- Vyas, P.; Gulati, A. Organic acid production in vitro and plant growth promotion in maize under controlled environment by phosphate-solubilizing fluorescent Pseudomonas. BMC Microbiol. 2009, 9, 174. [Google Scholar] [CrossRef]
- Bechtaoui, N.; Raklami, A.; Benidire, L.; Tahiri, A.I.; Göttfert, M.; Oufdou, K. Effects of PGPR co-inoculation on growth, phosphorus nutrition and phosphatase/phytase activities of faba bean under different phosphorus availability conditions. Pol. J. Environ. Stud. 2020, 29, 1557–1565. [Google Scholar] [CrossRef]
- Rfaki, A.; Nassiri, L.; Ibijbijen, J. Selection and Characterization of Phosphate Solubilizing Bacteria Isolated from the Rhizosphere of Three Cultivated Legumes in Morocco. Adv. Trends Biotechnol. Genet. 2019, 1, 119–129. [Google Scholar] [CrossRef]
- Chen, Q.; Liu, S. Identification and characterization of the phosphate-solubilizing bacterium Pantoea sp. S32 in reclamation soil in Shanxi, China. Front. Microbiol. 2019, 10, 2171. [Google Scholar] [CrossRef]
- Bashan, Y.; Kamnev, A.; de-Bashan, L. Tricalcium phosphate is inappropriate as a universal selection factor for isolating and testing phosphate—Solubilizing bacteria that enhance plant growth: A proposal for an alternative procedure. Biol. Fertil. Soils 2013, 49, 465–469. [Google Scholar] [CrossRef]
- Whitelaw, M.A. Growth promotion of plants inoculated with phosphate-solubilizing fungi. Adv. Agron. 2000, 69, 99–151. [Google Scholar] [CrossRef]
- Buono, N.I.; Ulla, E.L. Efectos de la inoculación con bacterias solubilizadoras de fosfato en tabaco (Nicotiana tabacum L.) y pimiento (Capsicum annuum L.) en condiciones controladas. Rev. Agron. Noroeste Argent. 2016, 36, 45–54. [Google Scholar]
- Magallon-Servin, P.; Antoun, H.; Taktek, S.; de-Bashan, L.E. Designing a multi-species inoculant of phosphate rock-solubilizing bacteria compatible with arbuscular mycorrhizae for plant growth promotion in low-P soil amended with PR. Biol. Fertil. Soils 2020, 56, 521–536. [Google Scholar] [CrossRef]
- Kumar, R.; Shastri, B. Role of phosphate-solubilising microorganisms in sustainable agricultural development. In Agro-Environmental Sustainability; Singh, J., Seneviratne, G., Eds.; Springer: Cham, Switzerland, 2017; pp. 271–303. [Google Scholar] [CrossRef]
- Glick, B.R. Modulation of plant ethylene levels by the enzyme ACC deaminase. FEMS Microbiol. Lett. 2005, 251, 1–7. [Google Scholar] [CrossRef]
- Yuan, L.; Li, L.; Zheng, F.; Shi, Y.; Xie, X.; Chai, A.; Li, B. The complete genome sequence of Rahnella aquatilis ZF7 reveals potential beneficial properties and stress tolerance capabilities. Arch. Microbiol. 2020, 202, 483–499. [Google Scholar] [CrossRef]
- Takahashi, H. Auxin biology in roots. Plant Root 2013, 7, 49–64. [Google Scholar] [CrossRef]
- Nath, D.; Maurya, B.R.; Meena, V.S. Documentation of five potassium-and phosphorus-solubilizing bacteria for their K and P-solubilization ability from various minerals. Biocatal. Agric. Biotechnol. 2017, 10, 174–181. [Google Scholar] [CrossRef]
- López, M.; España, M.; Toro, M. Efficiency of phosphorus absorption in you will cultivate of sorghum of different tolerance from the aluminum toxicity. Agron. Trop. 2007, 57, 205–218. [Google Scholar]
- Singh, M.; Dotaniya, M.L.; Mishra, A.; Dotaniya, C.K.; Regar, K.L.; Lata, M. Role of biofertilizers in conservation agriculture. In Conservation Agriculture: An Approach to Combat Climate Change in Indian Himalaya; Bisht, J.K., Meena, V.S., Mishra, P.K., Pattanayak, A., Eds.; Springer: Singapore, 2016; pp. 113–134. [Google Scholar] [CrossRef]
- Montes-Cruz, S.; Lalama-Aguirre, J.M.; Echeverría-Félix, J.M.; Salazar-Torres, S.M. Factores bióticos y abióticos que influyen en la aclimatación de las vitroplantas en invernadero. Dominio De Las Cienc. 2016, 2, 63–89. [Google Scholar] [CrossRef]
- Chien, S.N.; Prochnow, L.I.; Mikkelsen, R. Agronomic use of phosphate rock for direct application. RAE 2010, 75, 25. [Google Scholar]
- Castro, L.N.; Melgar, R. Rocas fosfóricas. Minerales para la agricultura en latinoamérica. Universidad Nacional de San Martín, Buenos Aires. Proyecto CYTED 2018, 13, 1–29. [Google Scholar]

| NBRIP–AlPO4 | NBRIP–FePO4 | NBRIP–Ca3(PO4)2 | |||||||
|---|---|---|---|---|---|---|---|---|---|
| Strain | Population (ufc/mL) | pH | mg/L P | Population (ufc/mL) | pH | mg/L P | Population (ufc/mL) | pH | mg/L P |
| AZO16M2 | 33 × 103 | 3.48 | 2.4 | 33 × 106 | 3.27 | 1.4 | 47 × 1010 | 4.4 | 29.6 |
| Strain | AIA (ppm) | Siderophores | Alkaline Phosphatase (µg pNP/mL/min) | Acid Phosphatase (µg pNP/mL/min) |
|---|---|---|---|---|
| AZO16M2 | 33.90 | (+) | 2.56 | 2.59 |
| Temperature (C°) | pH | Oxalic Acid 1 (µg/mL) | SD 2 | 2-Keto-Gluconic 1 Acid (µg/mL) | SD 2 | D-Gluconic 1 Acid (µg/mL) | SD 2 | |||
|---|---|---|---|---|---|---|---|---|---|---|
| 4 | 5.50 | 6.5373 | ab | 0.00802 | 4.3873 | c | 0.26034 | 13.8660 | i | 0.03012 |
| 6.80 | 6.5313 | ab | 0.01850 | 1.5193 | b | 0.03900 | 13.8683 | i | 0.12920 | |
| 8.50 | 6.5397 | ab | 0.00902 | 0.0000 | a | 0.00000 | 13.7850 | hi | 0.01229 | |
| 6 | 5.50 | 6.5320 | ab | 0.00985 | 6.0627 | d | 0.03573 | 13.7517 | hi | 0.06621 |
| 6.80 | 6.5277 | ab | 0.00929 | 8.6717 | e | 0.10340 | 13.6753 | h | 0.01986 | |
| 8.50 | 6.5377 | ab | 0.00723 | 0.0000 | a | 0.00000 | 11.4910 | g | 0.02081 | |
| 28 | 5.50 | 6.5680 | b | 0.00458 | 5.5910 | cd | 0.08266 | 9.3400 | e | 0.02443 |
| 6.80 | 7.0137 | d | 0.01250 | 8.3220 | e | 0.08800 | 7.3273 | a | 0.00902 | |
| 8.50 | 6.6770 | c | 0.03995 | 5.6997 | cd | 0.29612 | 7.5240 | b | 0.12450 | |
| 35 | 5.50 | 6.5380 | ab | 0.01652 | 6.3663 | d | 0.03623 | 10.0033 | f | 0.00723 |
| 6.80 | 6.4887 | a | 0.00902 | 8.0493 | e | 2.67808 | 8.9277 | c | 0.02532 | |
| 8.50 | 6.5790 | b | 0.08055 | 5.9113 | d | 0.60680 | 9.2110 | d | 0.12010 | |
| Strain | Phosphorus Source | Number of Leaves 1 (cm) | Plant Length 1 (cm) | Chlorophyll Content 1 (SPAD) | Aerial Fresh Weight 1 (g) | Aerial Dry Weight 1 (g) | Root Dry Weight 1 (g) | ||||||
|---|---|---|---|---|---|---|---|---|---|---|---|---|---|
| AZO16M2 | Ca3(PO4)2 | 7.8 | b | 13.9 | b | 55.28 | a | 8.89 | b | 0.83 | b | 1.33 | b |
| rock phosphate | 6.6 | a | 13.4 | a | 42.38 | a | 3.18 | a | 0.38 | a | 0.23 | a | |
| 2 B0 | Ca3(PO4)2 | 8.2 | b | 16.6 | b | 54.00 | a | 12.06 | b | 1.15 | b | 1.46 | b |
| K2HPO4 | 8.4 | c | 19.7 | c | 48.67 | a | 16.49 | cb | 1.38 | cb | 1.45 | c | |
| 3 P0 | 5.6 | a | 8.4 | a | 44.59 | a | 1.04 | a | 0.13 | a | 0.18 | a | |
| rock phosphate | 5.2 | a | 8.4 | a | 41.65 | a | 1.14 | a | 0.15 | a | 0.13 | a | |
| Strain | Phosphorus Source | N (%) | P (%) | K (%) | Ca (%) | Mg (%) |
|---|---|---|---|---|---|---|
| Control 1 B0 | K2HPO4 | 2.69 | 0.42 | 6.00 | 0.70 | 0.69 |
| Control 1 B0 | Ca3(PO4)2 | 3.53 | 0.21 | 4.91 | 0.83 | 0.85 |
| Control 1 B0 | rock phosphate | 3.53 | 0.10 | 3.90 | 0.83 | 0.82 |
| Control 1 B0 | 2 P0 | 2.83 | 0.12 | 5.70 | 0.60 | 0.81 |
| AZO16M2 | Ca3(PO4)2 | 3.16 | 0.15 | 5.23 | 0.73 | 0.63 |
| AZO16M2 | rock phosphate | 4.00 | 0.11 | 6.20 | 0.69 | 1.11 |
| Strain | Phosphorus Source | Root Length 1 (cm) | Aerial Fresh Weight 1 (g) | Root Fresh Weight 1 (g) | Chlorophyll Content 1 (SPAD) | ||||
|---|---|---|---|---|---|---|---|---|---|
| AZO16M2 | Ca3(PO4)2 | 39.30 | b | 20.23 | b | 35.68 | bc | 45.45 | a |
| rock phosphate | 25.80 | b | 18.91 | b | 23.98 | bc | 94.45 | a | |
| 2 B0 | Ca3(PO4)2 | 25.56 | b | 20.12 | b | 30.63 | bc | 38.16 | a |
| K2HPO4 | 21.74 | a | 8.97 | a | 8.65 | a | 35.39 | a | |
| 3 P0 | 27.20 | ab | 20.99 | b | 34.86 | c | 44.18 | a | |
| rock phosphate | 23.50 | b | 12.15 | b | 19.48 | b | 40.04 | a | |
| Strain | Phosphorus Source | N (%) | P (%) | K (%) | Ca (%) | Mg (%) |
|---|---|---|---|---|---|---|
| Control 1 B0 | K2HPO4 | 2.16 | 0.42 | 4.86 | 0.73 | 0.74 |
| Control 1 B0 | Ca3(PO4)2 | 2.46 | 0.42 | 5.69 | 0.85 | 0.52 |
| Control 1 B0 | rock phosphate | 2.32 | 0.40 | 2.75 | 0.80 | 0.73 |
| Control 1 B0 | 2 P0 | 2.04 | 0.40 | 4.15 | 2.15 | 0.50 |
| AZO16M2 | Ca3(PO4)2 | 2.27 | 0.41 | 5.79 | 0.60 | 0.65 |
| AZO16M2 | rock phosphate | 2.10 | 0.39 | 6.75 | 1.01 | 0.78 |
| Strain | Phosphorus Source | Survival (%) Sand:Vermiculite | Survival (%) Premix N°8 |
|---|---|---|---|
| Control 1 B0 | K2HPO4 | 75 | 50 |
| Control 1 B0 | Ca3(PO4)2 | 62.5 | 37.5 |
| Control 1 B0 | rock phosphate | 50 | 50 |
| Control 1 B0 | 2 P0 | 37.5 | 37 |
| AZO16M2 | Ca3(PO4)2 | 75 | 87 |
| AZO16M2 | rock phosphate | 25 | 25 |
Disclaimer/Publisher’s Note: The statements, opinions and data contained in all publications are solely those of the individual author(s) and contributor(s) and not of MDPI and/or the editor(s). MDPI and/or the editor(s) disclaim responsibility for any injury to people or property resulting from any ideas, methods, instructions or products referred to in the content. |
© 2023 by the authors. Licensee MDPI, Basel, Switzerland. This article is an open access article distributed under the terms and conditions of the Creative Commons Attribution (CC BY) license (https://creativecommons.org/licenses/by/4.0/).
Share and Cite
Landa-Acuña, D.; Toro, M.; Santos-Mendoza, R.; Zúñiga-Dávila, D. Role of Rahnella aquatilis AZO16M2 in Phosphate Solubilization and Ex Vitro Acclimatization of Musa acuminata var. Valery. Microorganisms 2023, 11, 1596. https://doi.org/10.3390/microorganisms11061596
Landa-Acuña D, Toro M, Santos-Mendoza R, Zúñiga-Dávila D. Role of Rahnella aquatilis AZO16M2 in Phosphate Solubilization and Ex Vitro Acclimatization of Musa acuminata var. Valery. Microorganisms. 2023; 11(6):1596. https://doi.org/10.3390/microorganisms11061596
Chicago/Turabian StyleLanda-Acuña, Daniela, Marcia Toro, Ricardo Santos-Mendoza, and Doris Zúñiga-Dávila. 2023. "Role of Rahnella aquatilis AZO16M2 in Phosphate Solubilization and Ex Vitro Acclimatization of Musa acuminata var. Valery" Microorganisms 11, no. 6: 1596. https://doi.org/10.3390/microorganisms11061596
APA StyleLanda-Acuña, D., Toro, M., Santos-Mendoza, R., & Zúñiga-Dávila, D. (2023). Role of Rahnella aquatilis AZO16M2 in Phosphate Solubilization and Ex Vitro Acclimatization of Musa acuminata var. Valery. Microorganisms, 11(6), 1596. https://doi.org/10.3390/microorganisms11061596








